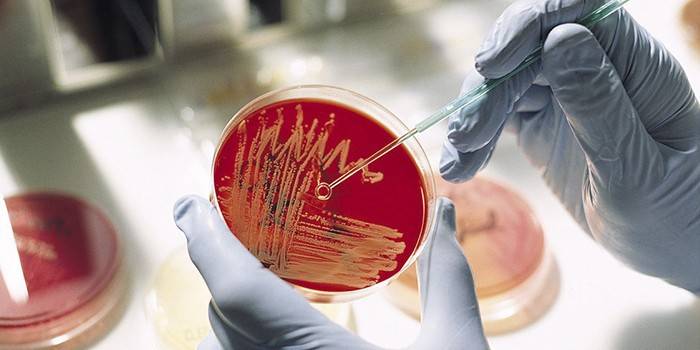

Extracelulárne a intracelulárne diplococci - spôsoby infekcie, príznaky, diagnostika a metódy liečby
Tieto baktérie sú patogénne, preto by nemali byť v zdravej mikroflóre. Takéto mikroorganizmy môžu spôsobovať choroby pľúc, urogenitálneho systému a meningov. Existujú rôzne druhy baktérií, ale liek je považovaný za najnebezpečnejší gonokok, meningokok a pneumokok. Reprodukujú sa za priaznivých podmienok, často pri znížení lokálnej imunity, keď je narušená rovnováha prospešných laktobacilov. Ak sa tieto škodlivé mikroorganizmy zistia v nátere, je potrebné určité ošetrenie.
Čo sú diplococci
Takzvané patogénne baktérie, ktorých prítomnosť naznačuje porušenie mikroflóry - dysbiózy, niekedy spôsobujú vážne ochorenie. Sú gram-pozitívne a gram-negatívne. Tieto sa považujú za zvlášť nebezpečné, pretože spôsobujú sexuálne prenosné choroby. „Diplo“ znamená, že baktérie sú spojené v pároch a majú hustú kapsulu. Mikroorganizmy sa niekedy môžu usporiadať do reťazí, hromád alebo dokonca náhodne. „Kokk“ znamená, že baktéria má guľový alebo zaoblený tvar.
druh
Podľa hlavnej klasifikácie sa rozlišujú gramnegatívne a grampozitívne diplokoky. Posledné uvedené sa vyznačujú tým, že počas štúdie zmenia farbu na fialovú. Navyše sa s nimi ťažšie lieči. Gramnegatívne baktérie nezafarbujú fialovú farbu a ich detekcia naznačuje gonokokovú infekciu. V závislosti od umiestnenia buniek sa v nátere nachádzajú extra- a intracelulárne diplokoky. Ich ďalšia klasifikácia je uvedená v tabuľke:
Názov diplococci |
vyhliadka |
rysy |
Spôsoby prenosu |
Aké systémy sú zarážajúce |
gonokokki |
Gram negatívny |
Najpatogénnejšie. Detegujú sa iba pomocou náteru a vysokej hladiny bielych krviniek. |
Sexuálna kontaktná domácnosť. |
Urogenitálne. Pri močení môže spôsobiť popálenie, žltý výtok s nepríjemným zápachom, hnisanie v maternici. |
meningokokmi |
Gram negatívny |
Vyznačuje sa nehybnosťou, nekonzistentnou kapsulou, citlivosťou na sušenie a nízkymi teplotami. |
Vo vzduchu, pretože je lokalizovaný v nosohltane a vylučuje sa kýchaním a kašľom. |
Dýchanie. Veľké krvinky kolónie meningokokov sa šíria krvným riečiskom, upchávajú malé cievy, poškodzujú miechu a mozog |
pneumokoky |
Gram pozitívne |
Má kapsulu, ktorá mu umožňuje prežiť v tele a spôsobiť ochorenie. V prostredí sú nestabilné, rýchlo varia a pôsobia dezinfekčné prostriedky. |
Aerogénne, t.j. vzduchovým mechanizmom. |
Dýchanie. Spôsobujú bolesť v oblasti hrudníka, dezorientáciu v priestore, strach zo svetla. |

Príčiny diplococci v nátere
Ak sa zistilo, že pacient má tento patogén, naznačuje to prítomnosť určitého ochorenia. Špecifická patológia závisí od typu detegovaných kokov. Za najnepríjemnejšie sa považuje gonokok, ktorý spôsobuje choroby genitourinárneho systému. U žien a mužov spôsobujú množstvo bežných patológií a sú charakteristické pre rovnaké pohlavie. Život pacienta ohrozujú meningokoky a pneumokoky, pretože ovplyvňujú mozog a miechu, respiračný systém.
U žien
Každá baktéria spôsobuje určité choroby. Gonokoky vyvolávajú vývoj kvapavky. Táto infekcia sa prenáša sexuálne a u žien sa môže objaviť po dlhú dobu bez akýchkoľvek príznakov. Kvapavka ovplyvňuje genitourinárne orgány. Gonokoková infekcia sa môže vyskytnúť vo forme:
- Gonokoková cervicitída. Je to zápal krčka maternice, ktorý je sprevádzaný bolesťou v dolnom bruchu, výtokom s hnisom, horúčkou a zhoršujúcim sa celkovým stavom.
- Anorektálna kvapavka. Ovplyvňuje konečník, spôsobuje svrbenie konečníka, opuch sliznice, praskliny a hnisavý výtok.
- Gonokoková vaginitída. Nebezpečná infekcia, ktorá, ak je chronická, vedie k neplodnosti. Naznačuje to pálenie a svrbenie pohlavných orgánov, penivý výtok, všeobecná intoxikácia.
U tehotných žien je niekedy diagnostikovaný gonokok. V tomto prípade je potrebné okamžite začať liečbu, aby sa zabránilo vývoju patológií u plodu. U novorodencov existuje vysoké riziko infekcie pri prechode cez pôrodný kanál alebo in utero. V prvom prípade sa infekcia prejavuje kvapavkovou vulvovaginitídou alebo hnisavou konjunktivitídou. Ak sa u pacienta zistí meningokok, diagnostikuje sa toto:
- meningococcemia;
- meningitída;
- artritída, endokarditída, iridocyclitída.
Tieto choroby sa najčastejšie zaznamenávajú pred dosiahnutím veku 30 rokov. Mnoho ľudí zomiera na pneumokokové infekcie. Šíria sa vzduchovými kvapkami, ktoré sa často podobajú akútnym respiračným infekciám. Riziko chorobnosti je zvlášť vysoké u detí, starších ľudí a žien s chronickými patológiami. Zoznam bežných infekcií zahŕňa:
- zápal pľúc;
- pneumokoková zápal stredného ucha;
- pneumokoková meningitída;
- zápal prínosových dutín.

V nátere u mužov, uretritída
Diplococci u mužov spôsobujú takmer rovnaké choroby ako u žien. V dôsledku meningokokov a pneumokokov sa vyvíjajú rôzne formy meningitídy a pneumónie. Kvapavka spôsobená gonokokmi sa u mužov častejšie diagnostikuje, rovnako ako uretritída kvapaviek. Inkubačná doba prvého ochorenia trvá 3 až 5 dní, ale u niektorých pacientov trvá až 3 týždne.
Infikovať môžete iba sexuálnym kontaktom s dopravcom. Z tohto dôvodu je vyššie riziko pre tých, ktorí majú promiskuitný sexuálny život. Kvapavka je čerstvá alebo chronická. Prvý je rozdelený do niekoľkých podtypov v závislosti od povahy príznakov:
- Akútna kvapavka. Sprevádza ju výtok z močovej trubice a pálenie v jej oblasti.
- Subakútna kvapavka.Objem sekrétov sa zväčšuje, stávajú sa hnisavými. Niektorí pacienti hlásia nepríjemný zápach. Symptómy sa postupne stávajú menej výraznými.
- Torpidálna kvapavka. Je sprevádzaná rovnakými príznakmi, ale ich závažnosť nie je tak jasná. Niekedy príznaky úplne chýbajú.

V dieťati
Pravdepodobnosť, že sa deti nakazia gonokokom, je veľmi nízka, pretože ešte nemajú sex. Aj keď je podľa názoru mnohých odborníkov táto baktéria schopná sa šíriť po domácnosti. Z tohto dôvodu sa môže dieťa nakaziť, ak niekto z rodiny má kvapavka. Pre deti je nebezpečnejší meningokok. Môže spôsobiť smrť za pár dní. Infekcia sa vyskytuje vo vzduchových kvapkách.
Meningokok ovplyvňuje nosohltanu a potom vstupuje do meningov. Ak sa tieto baktérie nachádzajú v nátere, je potrebné okamžité ošetrenie, pretože riziko úmrtia je veľmi vysoké. Pneumokoky môžu tiež ovplyvniť telo detí. Vlastnosti ich distribúcie:
- baktéria preniká do pľúc dieťaťa a spôsobuje ich porážku, čo je obzvlášť ľahké na pozadí anémie a nedostatku vitamínu;
- so zvyšujúcim sa počtom baktérií sa tiež nachádzajú v nátere z pohlavných orgánov;
- pneumokokové infekcie sú obzvlášť časté pri ARVI.

Príznaky prítomnosti diplococci
Znaky prítomnosti týchto patogénnych mikroorganizmov v tele závisia od ich typu. Gonokoky spôsobujú bolesť v dolnej časti brucha, dysfunkciu moču pri pálení a rezaní počas procesu, serózne hnisavý výtok z vagíny u žien a penisu u mužov. U silnejšieho pohlavia môže kvapavka spôsobiť:
- zápal očí;
- zápalový proces v konečníku;
- zápal sliznice krku;
- opuchy hlavy penisu;
- nočné erekcie s bolesťou.

Extracelulárne diplococci v nátere nemusia nevyhnutne znamenať kvapavka. Príčinou môže byť ďalšia gonokoková infekcia. Inak sa prejavuje prítomnosť pneumokokov v tele. Infekcia pokračuje ako akútne ochorenie dýchacích ciest, ale v závažnejšej forme. Označujú to nasledujúce znaky:
- bolesť v hrudníku;
- dýchavičnosť
- hypertermia;
- dýchavičnosť
- kašeľ;
- narušené vedomie.

Klinický obraz meningokokových infekcií je podobný ARI. Subfebrilná telesná teplota pretrváva 3 dni, hoci niekedy sa vôbec nezvýši. Nasledujúce nepríjemné príznaky obťažujú človeka:
- bolesť hlavy;
- hyperémia hltanu;
- mierne upchatie nosa;
- dráha hnisu a hlienu na zadnej strane hltanu;
- bolesť kĺbov a svalov;
- triaška;
- zvracanie.

diagnostika
Je ťažké potvrdiť špecifickú diagnózu iba podľa príznakov, ktoré sa pozorujú u pacienta. Z tohto dôvodu, ak existuje podozrenie na gonokokovú infekciu, je predpísaných niekoľko laboratórnych testov vrátane:
- očkovanie kultúry;
- všeobecná analýza moču;
- bakteriologická kultúra.
Hlavnou diagnostickou metódou je náter z močovej trubice alebo vagíny. Ak chcete získať čo najpresnejší výsledok, musíte opustiť intímne vzťahy 2 dni pred analýzou. Antibiotiká by sa mali vylúčiť ešte skôr - týždeň pred výsevom. V deň pred samotnou analýzou musíte opustiť intímnu hygienu a 2-3 hodiny pred ňou - močový mechúr nevyprázdňujte. Perineum môžete umyť iba v predvečer od náteru. Ženy by nemali používať vaginálne čapíky 2 dni pred analýzou.
liečba
Infekcie spôsobené týmto typom baktérií je ťažké liečiť, pretože postihujú niekoľko orgánov. Jednou z liečebných metód je fyzioterapia. Sú predpísané pre silné prepúšťanie z močovej trubice a výrazný opuch.Postup spočíva v zavedení špeciálnej injekčnej striekačky do močovej trubice alebo vagíny špeciálneho dezinfekčného roztoku, často založeného na furatsilíne. Na pozadí liečby je potrebné dodržiavať niekoľko pravidiel:
- vzdať sa alkoholu;
- nejedz slané a korenené jedlá;
- dodržiavať diétu odporúčanú lekárom;
- vylúčiť pohlavný styk;
- Nepoužívajte športy.

V prípade infekcie spôsobenej akýmkoľvek typom týchto baktérií sú potrebné antibiotiká. Vo všeobecnosti sa medzi drogami používajú tieto skupiny:
- penicilínové prípravky - ampicilín, bicilín-3, metronidazol, tinidazol;
- prípravky sulfónamidovej skupiny - biseptol;
- fluórchinolóny - Abactal;
- prípravky s laktobacilami - laktobaktínmi, bifidumbakterínmi;
- imunostimulačné činidlá - gonovaccín obsahujúci neaktívne formy gonokokov;
- antiseptické roztoky - miramistín, chlorhexidín.

Biseptol sa používa, ak ste alergický na penicilíny. Abaktal prináša dobrý výsledok. Stačí jedna dávka 600 mg. V chronickej forme trvá liečba 3 dni. Medzi bežne predpisované lieky na gonokokovú infekciu sa prideľujú tieto lieky:
- Biseptol. Obsahuje ko-trimoxazol. Dostupné vo forme tabliet a suspenzií. Sú indikované na liečbu kvapavky, pyelonefritídy, uretritídy, prostatitídy, pyelitídy, pohlavného lymfohaanu, epididymitídy. Biseptol sa užíva 4 tablety súčasne. Medzi dávkami je potrebné dodržať interval 6 hodín. Liečebný cyklus pozostáva zo 16 tabliet. Pri chronickej infekcii sa dávka zvyšuje na 20 kusov. Po ošetrení je potrebné znova vykonať test na náter. Výhodou biseptolu je jeho dobrá znášanlivosť.
- Bitsillin-3. Toto je kombinované antimikrobiálne činidlo s úzkou antibakteriálnou aktivitou. Antibiotikum je predstaviteľom penicilínov - liekov prírodného pôvodu, ktoré sa vyrábajú niektorými druhmi plesní. Inak sa liek nazýva benzylpenicilín. Používa sa na horúčku, erysipel, reumatizmus, angínu, infekcie rán, frambesia, syfilis. Pri kvapavke sa Bicilín-3 podáva vo forme 3 až 5 injekcií s prestávkou medzi nimi 3 dni. Priebeh liečby je určený povahou choroby. Výhodou je rýchly nástup terapeutického účinku.
- Laktobaktérie. Obsahuje živé laktobacily. Má antibakteriálnu, imunomodulačnú a normalizujúcu aktivitu mikroflóry. Laktobaktín sa používa na kvapavka, salpingitídu, chlamydiu, urogenitálny opar, atopickú dermatózu, salmonelózu. Dávka pre dospelých je 5 dávok 2-3 krát denne. Maximálna denná dávka - 15 dávok. Výhodou lieku je možnosť použitia na pozadí antibiotickej terapie.
- Chlórhexidín. Obsahuje látku rovnakého mena, má antiseptický účinok, najmä baktericídny. Plus - pri lokálnej aplikácii nemá systémový účinok na organizmus. Liek je indikovaný na trichomoniázu, herpes genitálií, chlamydiu, kvapavku, chlamydiu. Muži by si mali vpichnúť 2 až 3 ml lieku do močového kanálika a ženy - 1 až 2 ml do močového kanála a 5 až 10 ml do pošvy. Výhoda lieku pri zriedkavom výskyte vedľajších účinkov.

prevencia
Najbežnejšou cestou infekcie týmito baktériami je genitália. Z tohto dôvodu je dôležité vylúčiť promiskuitné sexuálne kontakty, používať kondómy a dodržiavať pravidlá osobnej hygieny. Na odstránenie infekcie gonokokmi, meningokokmi alebo pneumokokmi vám pomôžu nasledujúce odporúčania:
- odmietnutie zlých návykov;
- správna výživa;
- pravidelné pranie bielizne a tela;
- prevencia závažného nervového vyčerpania;
- posilnenie imunity;
- použitie po nebezpečnom pohlavnom styku chlorhexidín alebo Miramistín;
- Počas epidémií sa vyhnite navštevovaniu preplnených miest.
